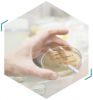
CPS výzkumná skupina Bioaktivní polymerní systémy

Research direction
Contacts
Management
This email address is being protected from spambots. You need JavaScript enabled to view it.
Copyright 2017 © Centrum polymerních systémů. Všechna práva vyhrazena
Dodavatel webu: Digitální #agentura Weboo
Dodavatel webu: Digitální #agentura Weboo